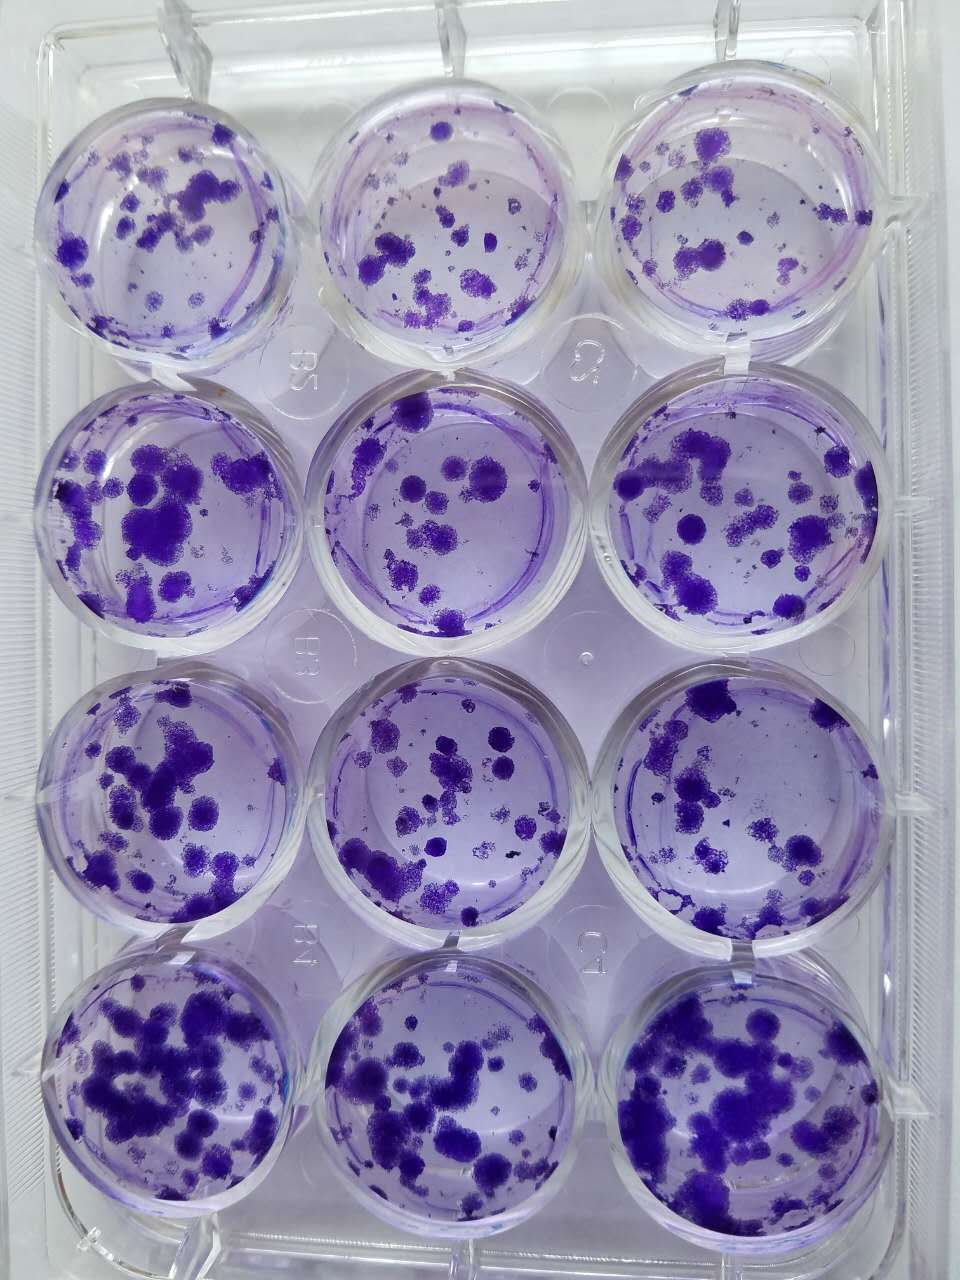

技术服务
细胞增殖检测
目前主要有两种用于检测细胞增殖能力的方法。一种是直接的方法,通过直接测定进行分裂的细胞数来评价细胞的增殖能力。另一种是间接的方法,即细胞活力(cell viability)检测方法,通过检测样品中健康细胞的数目来评价细胞的增殖能力。显然,细胞活力检测法并不能最终证明检测样品中的细胞是否在增殖。如细胞在某一培养条件下会自发启动凋亡程序,但药物的干扰可抑制凋亡的发生;这时若采用细胞活力检测法,显然可以区分两种条件下的细胞数量,但我们并不能从药物干扰组细胞数大于对照组的事实说明药物可促进细胞增殖的结论。所以最直接的证据应该采用方法一。
博奥科提供的主要有CCK8检测法 ,MTT检测法,Brdu检测法,Edu检测法,平板克隆形成。

客户提供:
1、冻存的细胞或者生长状况良好的细胞株,培养条件及相关注意事项(或由本公司提供或代购)
2、细胞处理试剂
3、实验方案
研拓生物提供:
1、实验过程影响资料
2、实验报告(实验仪器及厂家;实验试剂及厂家批号;实验步骤;实验结果)
3、原始实验图片及数据

